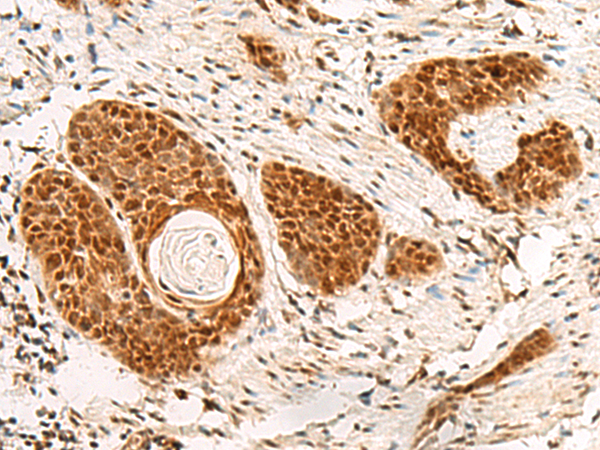

中文名稱 : 兔抗POM121多克隆抗體
英文名稱 : Anti-POM121 rabbit polyclonal antibody
別 名 : POM121 transmembrane nucleoporin; P145; POM121A
儲(chǔ) 存 : 冷凍(-20℃)
抗 原 : POM121
宿 主 : Rabbit
反應(yīng)種屬 : Human
相關(guān)類別 : 一抗
標(biāo) 記 物 : Unconjugate
克隆類型 : rabbit polyclonal
技術(shù)規(guī)格
|
Background: |
This gene encodes a transmembrane protein that localizes to the inner nuclear membrane and forms a core component of the nuclear pore complex, which mediates transport to and from the nucleus. The encoded protein may anchor this complex to the nuclear envelope. There are multiple related genes and pseudogenes for this gene on chromosomes 5, 7, 15, and 22. Alternatively spliced transcript variants encoding different isoforms have been observed. |
|
Applications: |
ELISA, IHC |
|
Name of antibody: |
POM121 |
|
Immunogen: |
Fusion protein of human POM121 |
|
Full name: |
POM121 transmembrane nucleoporin |
|
Synonyms: |
P145; POM121A |
|
SwissProt: |
Q96HA1 |
|
ELISA Recommended dilution: |
5000-10000 |
|
IHC positive control: |
Human thyroid cancer and Human cervical cancer |
|
IHC Recommend dilution: |
40-200 |

購(gòu)物車
幫助
021-54845833/15800441009
